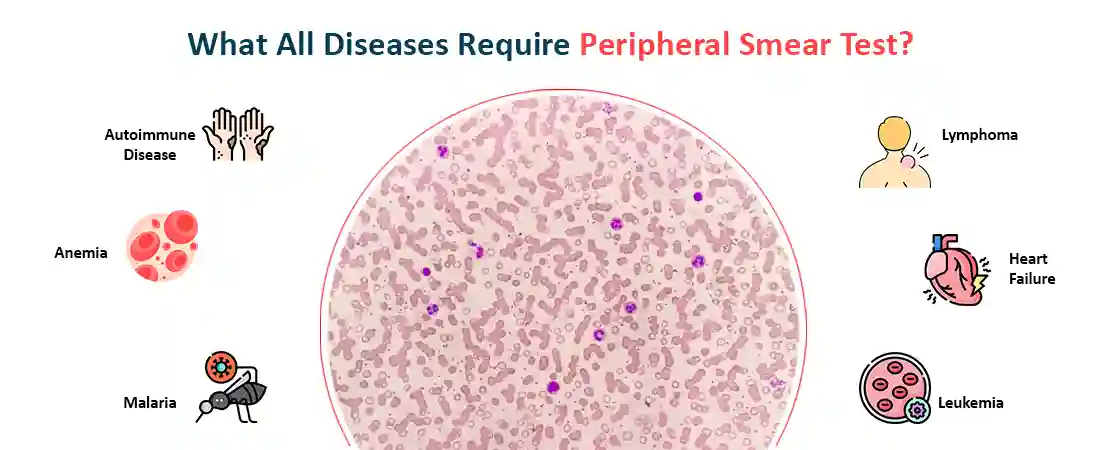

With the word play of Lab work and Blood Tests, we try and understand the important part of our health. As correctly said and I quote, “Your blood work doesn’t lie”. It is utmost important to understand your health and get comprehensive blood tests done for you and the family.
The examination of the peripheral blood smear should be considered, along with review of the results of peripheral blood counts and red blood cell indices, an essential component of the initial evaluation of all patients with hematologic disorders.
Overview of Peripheral Blood Smear
Wright's stain analysis of blood films frequently yields crucial information for the diagnosis of anemia and other illnesses involving leukocytes and platelets.
Your healthcare provider may be able to determine why and how your blood cells appear abnormal or why you have an abnormally high cell count with the use of a microscopic view of your cells.
Note: If your complete blood count (CBC) is abnormal, you could require a blood smear. A standard test that evaluates several distinct components of your blood is called a CBC.
What is the use of Wrights Stain?
The Wright's stain is considered to be a hematologic stain that aids and facilitates in your differentiation of the blood cell types. It is in general a mixture of your eosin (red) and the methylene blue dyes. It would also be used in staining the peripheral blood smears, the urine samples, and any bone marrow aspirates, which could be examined under the light microscope.
In case of the cytogenetic, it will be used in the chromosomal analysis to facilitate any diagnosis of the syndromes and any diseases.
What is the use of Peripheral Smear Test?
A blood smear is used to help diagnose and monitor many conditions, such as blood disorders, sudden kidney failure, and treatment for certain cancers.

Other Conditions that may require a Peripheral Blood Smear are as follows:
-
Your symptoms could be signs of other diseases or blood abnormalities. Medical professionals are aware that particular disorders are linked to specific alterations in blood cells or platelets. PBS results complement the diagnosis that medical professionals develop; they do not constitute a diagnosis in and of themselves.
-
Your healthcare physician is interested in learning more about your bone marrow and blood cells because you may be a candidate for a stem cell transplant.
-
You are being treated for a health issue. Peripheral blood smear tests could be prescribed by medical professionals to determine the efficacy of your treatment.
What all Cells are checked in Your Peripheral Smear Test?
-
Red Blood Cells: With a mean diameter of approximately 7.5 μm, normal human red blood cells are biconcave disks, sometimes known as diskocytes. Compared to tiny lymphocytes, erythrocytes are somewhat smaller. Red blood cells have peripheral hemoglobin, which leaves a center pallor that makes up between 30 and 45 percent of the cell's diameter.
-
White blood cells: A vital component of your immune system, white blood cells aid in defending your body against infections. White blood cell types are divided into five categories. Every kind combats illness in a unique way.
-
Platelets: Platelets aid in the clotting of blood. A low platelet count could indicate cancer, infections, or other medical issues.
What all Diseases require Peripheral Blood Smear?
The diseases that require a Peripheral Blood Smear Test are as follows:
In case of Abnormal Cell Count, the PBS is required in the following conditions:
A. Abnormal RBC Conditions
B. Abnormal WBC Conditions
C. Abnormal Platelet Count Conditions
-
Thrombocytopenia : It is known to be a condition in which your blood doesn't have enough platelets, which increases the risk of bleeding
-
Inherited platelet disorders (uncommon), such as the Bernard-Soulier Syndrome
What is the Technique used In Peripheral Blood Smear?
By using an oil immersion lens to examine carefully produced films of peripheral blood stained with Wright's stain under a microscope, morphologic abnormalities of peripheral blood cells can be found.
When erythrocytes are examined far out on the feathered edge, they show no core pallor; but, in thick sections of the slide, cell contact has deformed the erythrocyte (RBC) shape.
Guidelines to follow before, during and after the Peripheral Smear Testing
Here are some guidelines an individual can refer to once they have decided to undergo Peripheral Blood Smear Tests in Ganesh Diagnostic and Imaging Center
The required documents needed for this test includes your valid government ID and an appropriate Doctor’s prescription.
A. Before the Test
The preparation for multiple tests for Peripheral Blood testing may require some preparation ahead.
Usually, Fasting is not required before the test. But, it is recommended to consult your doctor before undergoing Peripheral Blood Test.
In case, you undergo multiple tests along with Peripheral Blood Smear, your doctor might recommend fasting to be done.
B. During the Test
During the blood test, the doctor would take the blood sample from the vein in your arm, using the small needle.
Then, a small amount of blood would be drawn and collected into the corresponding test tube or the vial.
You might feel a little sting when the needle pricks or while it is being removed. This would usually take less than even five minutes.
C. After the Test
There would be slight tenderness at the injection site without any major concern. This patient is expected to get back to their daily life immediately.
What are the results and Follow-up of the Peripheral Blood Smear?
Peripheral blood smear tests are ordered by medical professionals for specific purposes.
Note: Your healthcare professional is doing a peripheral blood smear test to find out additional information because your CBC may have revealed an odd result.
A peripheral blood smear test will assist your healthcare professional in determining the reason of any symptoms you may be experiencing. But they will explain the significance of the findings and why they suggest a peripheral blood smear test.
For Free Consultation from the Doctor
Contact- Dr. Ravin Sharma, (MBBS, MD in Radiology)
Available: 24*7*365
Phone Number: +919212125996
Why should Ganesh diagnostic and Imaging Centre be your preference for getting Peripheral Blood Smear Test done?
At Ganesh Diagnostic and Imaging Centre, we are known for providing excellent service and care to its patients for decades. Lakhs of satisfied patients over the years!
It is an established and renowned diagnostic centre since 2001.
Their excellence is backed by NABH and NABL Accreditations.
NABH accreditation is proof of highest standard of care and service provided to the patients. NABL accreditation reflects the competency of laboratories and equipment based on some national and international standards.
Test report is available digitally too.
Ganesh Diagnostic and Imaging Centre is a one-stop solution for getting all kinds of tests done, as all services are available under one roof.
The aim of GDIC is to provide world’s finest technology at the lowest price.
We provide trained staff and technicians that would aid in the success of your sample collection. We also provide Free Ambulance Service, to combat any mobility issues for both pick and drop service for our patients.
The rates of scans are reasonably priced. Ganesh Diagnostic and Imaging Centre also offer FLAT 50% OFF on many tests.
Patients can rely upon test reports as reports are 100% accurate.
The cost of the Peripheral Smear in Delhi, at Ganesh Diagnostic and Imaging Center are as follows.
The Tests that are conducted at Ganesh Diagnostic and Imaging Center are as follows:
- Blood Picture; Peripheral Blood Smear Examination
- CBC With Peripheral Smear
- Giemsa Stain, Peripheral Blood/Bone Test
- Peripheral Blood Smear
Cost of Peripheral Blood Smear Tests in Delhi
The Serum Blood Tests vary by region and facility. So constantly get tested at trustworthy diagnostic centers like Ganesh Diagnostic. It is staffed by trained and experienced professionals to assure patient and visitor safety.
There are multiple tests that are done to monitor any Hormonal issues leading to Peripheral Blood Smear
So get your Peripheral Blood Tests done your nearest Ganesh Diagnostic Center.
Book Your Online Test and Get Early Appointment
Ganesh Diagnostic Center promotes great care and concern for patients.
It is our utmost duty to allow a speedy diagnosis and hope that in future, your treatment is done at the earliest.
Thus, we recommend you to book an appointment with us today and book your online blood test for any specific disease, disorder and discomfort.
Apart from this, we also provide Free Ambulance Service to our patients who wish to visit our center for Sample Collection, inclusive of both pick up and drop off service for our patients.
Avail our digital support system and establish a long lasting relationship with Ganesh Diagnostic Center near you today. Book Now!
Blood Home Sample Collection
Obtaining blood samples for diagnostic testing at home is a practical and efficient method. Patients with mobility challenges, hectic schedules, or trouble traveling can benefit from this method.
We provide highly skilled phlebotomists to do blood and urine tests at your home. Comfort, quickness, and ease are provided by home blood sample tests. Booking online for home collection services is quite simple. Book Now!
Schedule a home collection and get reports from anywhere, at any time!
Note from Ganesh Diagnostic & Imaging Center
Early checkups are always better than delayed ones. Safety, precaution & care are depicted in the several health checkups at our center.
Here, at Ganesh Diagnostic and Imagining Center, we present simple & comprehensive health packages for any kind of testing to ensure the early prescribed treatment to safeguard your health.
So, visit us at the earliest to ensure good health and to maintain an active immune system
The rates of scans are reasonably priced. Ganesh Diagnostic and Imaging Centre also offer FLAT 50% OFF on many tests.
Call Now for Free Home Sample Collection Service
If you have any query, contact us
Frequently Asked Questions (FAQs) on Peripheral Blood Smear Test
What is the principle of peripheral blood smear?
The blood smear or also named as peripheral blood smear or the blood film is considered to be thin layer of the blood that is smeared on your glass microscope slide and then it will be stained in a way to allow blood cells to be examined microscopically.
Also called or termed as follows: PBS- Peripheral Blood Smear, PBF- Peripheral Blood Film
Why is a blood smear done?
The blood smear test is often done to diagnose conditions that are causing:
- Unexplained Jaundice
- Abnormal Bruising
- Unexplained Anemia
- Persistent Flu-Like Symptoms
- Unexpected Or Severe Infection
- Sudden Weight Loss
- Skin Rashes
- Bone Pain
What information can you gather from a peripheral smear?
The smear will also provide the following information such as: Number and types of WBC (includes the differential, or the percentage of each type) . Number and the kinds of any abnormally shaped blood cells. It will give you a rough estimate of the white blood cell and also your platelet counts.
Which stain is used for peripheral blood smear?
Your Common stains that would be used in Leishman stain are composed of polychrome methylene blue (the basic component) and the eosin (acidic component). The May-Grunwald Giemsa or the Wright-Giemsa stain could also be used.
What color tube is used for peripheral smear?
The Whole blood sample that would be collected in the EDTA purple-top tube. The Capillary specimen that is collected in the EDTA micro tube. This tube in general must contain about 375 mcl (bottom line) for it being acceptable for any testing procedure.
What are the risks involved with Peripheral Blood Testing?
This Peripheral Smear blood test is considered to be low-risk procedure. However, the minor risks include the following:
What are the components of peripheral blood smear?
Peripheral Blood
The components of the PBS are as follows:
- Erythrocytes
- Platelets
- Leukocytes
- Monocytes.
- Lymphocytes
- Bruising
- Neutrophils
- Eosinophils
- Basophils.
Can I take the test at home?
Due to any nature of the peripheral blood test and the sample collection, your blood smear would not be done at home and this would have to be administered by the health professional.
What are the factors in making a peripheral blood smear?
The 3 factors that would be altered slightly to produce perfect blood smear are as follows: Speed, Angle and Drop Size. The faster your spreader slide moves, the longer also thinner would be the film. When film is over slower, the shorter and the thicker would move.